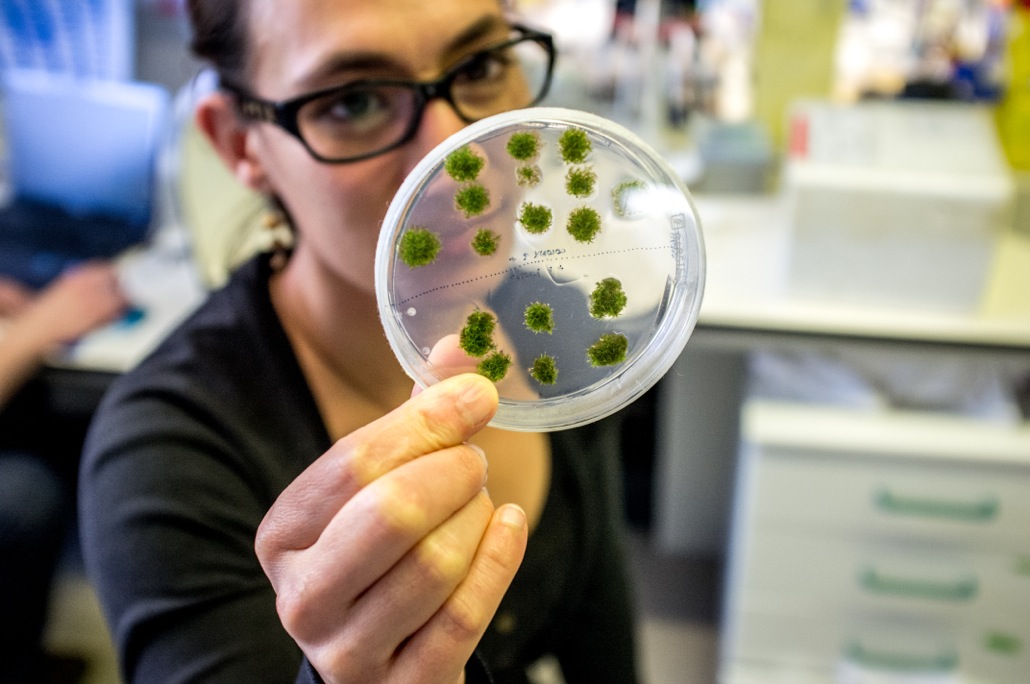
JBecker_ERA_CAPS

Um consórcio europeu e norte-americano coordenado por Jörg Becker, investigador principal no Instituto Gulbenkian de Ciência (IGC; Portugal), recebeu agora financiamento de 2.6 milhões de euros por 3 anos para estudar a evolução da reprodução sexual das plantas. O projeto é financiado pela ERA-CAPS, uma rede europeia dedicada a apoiar atividades de investigação no campo da Ciência das Plantas. Este estudo irá possibilitar a identificação de genes úteis para a indústria agrícola, com o objetivo de melhorar a reprodução de espécies de cultivo e aumentar a sua produtividade.
As plantas com semente são extremamente importantes economicamente, pois são a nossa fonte principal de alimento, fibras e outras matérias-primas industriais. No entanto, a nossa capacidade de gerar comida suficiente, ração para animais e energia está cada vez mais comprometida pela expansão da população humana, pela competição pelo uso de terra, pela rápida perda de biodiversidade e pela mudança climática global. É, portanto, crucial estudar o processo da reprodução sexual das plantas de forma a superar problemas de fertilização e aumentar o rendimento de colheitas.
O projeto agora financiado reúne vários investigadores líderes na área da reprodução das plantas. Os oito parceiros são Jörg Becker, Frederic Berger, Thomas Dresselhaus, Stefanie Sprunck, David Twell, Marek Mutwil e Jose Gutierrez-Marcos, da Europa, e Mark Johnson, dos EUA. Usando diversas espécies como modelos de estudo, desde musgos até plantas com flor, os investigadores pretendem compreender as principais etapas na evolução da reprodução das plantas, incluindo os mecanismos ancestrais de desenvolvimento dos gâmetas e fertilização.
Jörg Becker diz: “Este projeto é uma oportunidade única para maximizar sinergias e evitar duplicação de esforços de investigação. Cada parceiro traz para o projeto as suas competências técnicas únicas e complementares, o que deverá permitir uma compreensão mais profunda da evolução da reprodução sexual de espécies de plantas economicamente importantes”.
Para isso, os investigadores pretendem estudar a evolução de redes regulatórias importantes para o desenvolvimentos dos gâmetas masculino e feminino, crescimento do tubo polínico e mecanismos de fertilização em plantas com flor. Irão comparar a atividade de redes de genes em plantas terrestres primitivas, tais como musgos, com outras plantas importantes de cultura, como milho e tomate. Esta abordagem genómica comparativa irá ajudar na identificação dos principais mecanismos de reprodução das plantas e revelar se são ancestrais ou novos. O grupo de investigação de Jörg Becker, no IGC, irá focar os seus estudos no desenvolvimento de células de esperma do musgo Physcomitrella patens, e na forma como alterações que não estão escritas diretamente no DNA podem ser transmitidas mediante a fertilização.
“O nosso projeto irá fornecer a primeira análise exaustiva da evolução molecular da reprodução sexual das plantas e dar informações sobre as origens da fertilização em plantas com flor. Isto é fundamental para podermos desenvolver ferramentas para manipular a reprodução das plantas a nosso favor e melhorar a produtividade das culturas”, diz Jörg Becker.
A ERA-CAPS foi lançada em 2012, sendo o seu financiamento oriundo das respectivas agências de financiamento de cada país participante. Esta é a primeira vez que Portugal participa num projeto da ERA-CAPS, não só como parceiro mas também como coordenador. Além do Instituto Gulbenkian de Ciência (Portugal), as outras instituições participantes são: Gregor Mendel Institute (Áustria), Universidade de Regensburg (Alemanha), Universidade de Leicester (Reino Unido), MPI Molecular Plant Physiology (Alemanha), Universidade de Warwick (Reino Unido) e Universidade de Brown (EUA).
Neste projeto da ERA-CAPS, a investigação realizada no Instituto Gulbenkian de Ciência é financiada pela Fundação para a Ciência e a Tecnologia (FCT).
Legenda: O musgo Physcomitrella patens serve como modelo da reprodução de plantas terrestres primitivas. A imagem mostra colónias do musgo a crescer em placa em laboratório. Créditos: Roberto Keller, IGC.